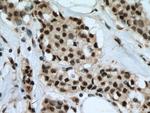
LARP7 Antibody in Immunohistochemistry (Paraffin) (IHC (P))

Search
Proteintech
LARP7 Polyclonal Antibody
{{$productOrderCtrl.translations['antibody.pdp.commerceCard.promotion.promotions']}}
{{$productOrderCtrl.translations['antibody.pdp.commerceCard.promotion.viewpromo']}}
{{$productOrderCtrl.translations['antibody.pdp.commerceCard.promotion.promocode']}}: {{promo.promoCode}} {{promo.promoTitle}} {{promo.promoDescription}}. {{$productOrderCtrl.translations['antibody.pdp.commerceCard.promotion.learnmore']}}
产品信息
17067-1-AP
种属反应
已发表种属
宿主/亚型
分类
类型
抗原
偶联物
形式
浓度
规格
纯化类型
保存液
内含物
保存条件
运输条件
产品详细信息
Immunogen sequence: LTTDGKLIA RALRSSAVVE LDLEGTRIRR KKPLGERPKD EDERTVYVEL LPKNVNHSWI ERVFGKCGNV VYISIPHYKS TGDPKGFAFV EFETKEQAAK AIEFLNNPPE EAPRKPGIFP KTVKNKPIPA LRVVEEKKKK KKKKGRMKKE DNIQAKEENM DTSNTSISKM KRSRPTSEGS DIESTEPQKQ CSKKKKKRDR VEASSLPEVR TGKRKRSSSE DAESLAPRSK VKKIIQKDII KEASEASKE (83-331 aa encoded by BC006981)
靶标信息
LARP7 gene ontology annotations related to this gene include RNA processing.
仅用于科研。不用于诊断过程。未经明确授权不得转售。
生物信息学
蛋白别名: DKFZP564K112; hLARP7; La ribonucleoprotein domain family member 7; La-related protein 7; LARP7; P-TEFb-interaction protein for 7SK stability; PIP7S
基因别名: ALAZS; C330027G06Rik; D3Wsu161e; HDCMA18P; hLARP7; LARP7; PIP7S
UniProt ID: (Human) Q4G0J3, (Rat) Q5XI01, (Mouse) Q05CL8
Entrez Gene ID: (Human) 51574, (Rat) 686883, (Mouse) 28036